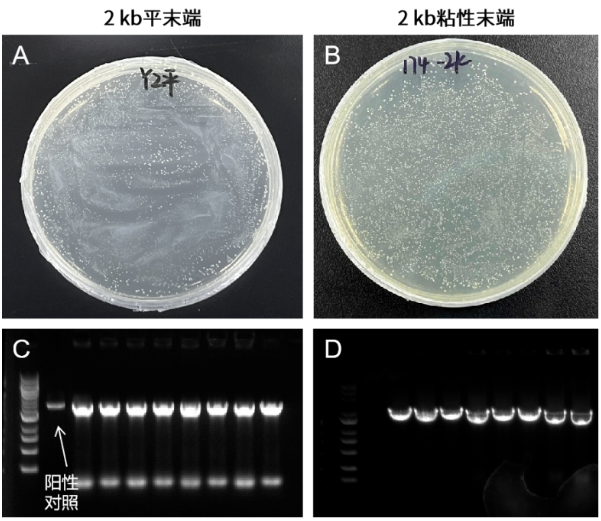
新闻图片5

19 年
手机商铺
入驻年限:19 年
翌圣生物
上海
体外诊断、耗材、技术服务、抗体、ELISA 试剂盒、细胞库 / 细胞培养、试剂
生产厂商
公司新闻/正文
3612 人阅读发布时间:2023-10-16 09:44
克隆是英文“clone”或“cloning”的音译,而英文“clone”则起源于希腊文“Klone”,原意是指以幼苗或嫩枝插条。1963年J.B.S.Haldane在题为“人类种族在未来二万年的生物可能性”的演讲上采用“克隆(Clone)”的术语,把“克隆技术”带到了人们的视野中。
克隆技术又称为“生物放大技术”,目前应用最广泛的技术为“分子克隆”,又称重组DNA技术,即通过重组技术将目的DNA片段按照人们的设计定向连接起来,在特定的受体细胞中与载体同时复制并得到表达,产生新的遗传性状的技术。
随着分子生物学研究的不断深入,分子克隆技术也随之更新迭代,从传统的依赖限制性内切酶的方法发展到如今的TA克隆、TOPO克隆、无缝克隆、Gateway技术等等,新的技术不断涌现,为分子生物学的发展和进化提供新的力量。今天小翌就带领大家认识一下不同的分子克隆方法。
01 传统分子克隆技术
传统分子克隆技术的依赖于限制性内切酶和酶切位点。主要步骤是通过限制性内切酶(翌圣的FuniCut™快速限制性内切酶Cat#15001ES-15051ES)酶切载体和目的基因,通过连接酶(翌圣T4 DNA连接酶Cat#10300)将酶切的片段拼接在一起(即连接过程),形成可以表达目的基因的新载体(即重组质粒),使用转化技术转化至感受态细胞中,进而实现目的基因的扩增、转录和翻译。
传统分子克隆实验流程如下图:

图1.传统分子克隆实验流程
该技术最早由Cohen Group在1973年实现,他们将E.coli的tetr质粒psclol和nersrR6-3质粒体外限制酶切割,连接成新的质粒,转化E.coli,在含四环素和新霉素的平板上筛选出了terrNer,实现了细菌遗传性状的转移。传统分子克隆技术较为成熟,但是该方法受到限制性酶切位点和连接效率等方面的限制,并不能高效、准确的克隆需要的目的基因。

图2. Stanley Cohen和Herbert Boyer(第一个成功实现基因工程技术的团队)
02 TA克隆 TA克隆(Original TA Cloning Kit),依赖于PCR反应中所使用的聚合酶具有末端转移的活性,通常在克隆片段的3’末端加上A尾(即3’-A),通过连接酶(翌圣T4 DNA连接酶Cat#10300)把克隆片段与一个具有3’-T突出的载体DNA连接起来。主要应用于不清楚目的基因DNA序列的实验,通过TA克隆重组到T-载体后,使用T-载体的上下游引物扩增片段,测序,最终确定目的基因序列。其中,聚合酶的选择尤为重要,翌圣普通PCR试剂盒(Cat#10102/10103/10157)、翌圣快速PCR试剂盒(Cat#10157)均具有Taq DNA聚合酶,扩增后的PCR产物具有3’-dA突出端,可轻松克隆至T载体。

图3. TA克隆流程示意图【3】
03 TOPO克隆 TOPO克隆技术是通过TOPO载体上偶联的异构酶(Topoisomerase)实现插入片段的快速克隆。其原理是利用Topo载体两端通过磷酸键偶联的Topo酶,在连接反应中,受插入片段的5'端羟基的攻击,磷酸键释放能量。利用该能量,插入片段5'端羟基与载体片段3'端磷酸基团连接在一起,Topo异构酶从载体分子上脱落,完成连接反应。不同于传统的TA克隆,TOPO克隆能够在2-5 min内快速完成插入片段和载体的连接反应,操作简单,连接效率极高。

图4. TOPO克隆原理
目前市面上的产品,需根据DNA片段末端的不同,选择不同的TOPO克隆试剂盒。而翌圣新品零背景通用型TOPO克隆试剂盒(Cat#10906),能够兼容平末端产物或粘性末端产物,不受片段末端影响,快速克隆连接,效率高,阳性率接近100%,如图5所示。
图5. TOPO TA/Blunt克隆试剂盒轻松连接2 kb(10 ng)平末端/粘性末端片段
注:A&B:TOPO克隆转化平板。C&D:插入片段PCR鉴定电泳图。
04 无缝克隆技术 传统克隆和TA克隆两种方法费时费力,过程繁冗,为了解决限制性酶切位点的限制,科学家们研发出新的、快速、简洁、高效的克隆技术——无缝克隆,区别于传统分子克隆,差异在于载体末端和引物末端应具有15-20个同源碱基,由此得到的PCR产物两端便分别带上15-20个与载体序列同源性的碱基,依靠碱基间作用力互补配对成环,不经过酶切,PCR产物和线性化载体在同源重组酶的作用下,经过一定的时间和温度即可进行转化,完成定向克隆。

图6.同源重组原理
无缝克隆技术最早是2009年由Daniel Gibson和J. Craig Venter发展起来,广泛应用的方法包括两种Gibson Assembly和In-Fusion Cloning,原理都是通过外切酶产生黏性末端,再通过同源重组酶的连接得到重组片段,但是两种方法的外切酶完全不同,形成重组序列的方式也不一样。

图7. Gibson Assembly原理图【5】
In-Fusion Cloning:具有3’→5’ 核酸外切酶,能够识别3’末端碱基,沿着3’→5’ 方向降解dsDNA,产生5’黏性末端,同源臂互补,退火后配对,因为其不含连接酶,所以要将重组片段转化到感受态细胞内,序列中的缺口会在感受态体内补平、连接,获得重组片段。

图8. In-Fusion Cloning原理【6】
翌圣同源重组试剂盒利用无缝克隆技术,仅需50℃反应20 min即可转化,完成定向克隆,克隆阳性率可达95%以上。其中,翌圣一步法快速克隆试剂盒(Cat#10911ES)可连接单片段,该试剂盒已发文章累计IF达到1000+。翌圣通用型一步法快速克隆试剂盒(Cat#10922ES)可连接1-6片段,最长连接片段可达23 kb,是多片段连接的不二之选。 通过上述的介绍,相信大家已经初步了解了目前实验室中常用的分子克隆技术,那么还有哪些新开发的分子克隆技术呢?无缝克隆中不常见、特殊的分子克隆技术又有哪些呢?关注我们,小翌会在下一期的分子克隆技术专题中,给大家介绍新的分子克隆技术,为您的实验带来新的思路与方向,期待下一次的见面~05 相关产品列表
| 产品定位 |
产品名称 |
产品货号 |
规格 |
| 通用缓冲液,5min完成精准酶切 |
FuniCut™快速限制性内切酶 |
50 T |
|
| 常规PCR |
2×Hieff® PCR Master Mix(With Dye) |
1 mL/5×1 mL |
|
| 常规PCR,不含染料 |
2×Hieff® PCR Master Mix(No Dye) |
1 mL/5×1 mL |
|
| 快速PCR,快至1s/kb |
2×Hieff® Ultra-Rapid HotStart PCR Master Mix(with Dye) |
1 mL/5×1 mL |
|
| TOPO克隆-兼容TA/平末端 |
Hieff Clone® Universal Zero TOPO TA/Blunt Cloning Kit |
20 T |
|
| TOPO克隆-TA末端 |
Hieff Clone® Zero TOPO-TA Cloning Kit 零背景TOPO-TA克隆试剂盒 |
20 T |
|
| TOPO克隆-平末端 |
Hieff Clone® Zero TOPO-Blunt Cloning Kit |
20 T |
|
| 单片段一步克隆,已发文章累计IF达到1000+ |
Hieff Clone® Plus One Step Cloning Kit一步法快速克隆试剂盒 |
10911ES20/50 |
20 T/50 T |
| 1-6片段一步克隆,最快5分钟完成重组反应 |
Hieff Clone® Universal One Step Cloning Kit通用型一步法快速克隆试剂盒 |
20 T/50 T |
参考文献
1.Barany F. Genetic disease detection and DNA amplification using cloned thermostable ligase[J]. Proc Natl Acad Sci USA, 1991, 88(1), 189-193.
2.Holton TA, Graham MW. A Simple and efficient method for direct cloning of PCR products using ddT-tailed vectors[J]. Nucleic Acids Res, 1991, 19(5), 1156.
3.Clark D P, Pazdernik N J, Mcgehee M R. Cloning Genes for Synthetic Biology - ScienceDirect[J]. Molecular Biology (Third Edition), 2019:199-239.
4.Seki T, Seki M, Onodera R, et al. Cloning of cDNA encoding a novel mouse DNA topoisomerase III (Topo IIIbeta) possessing negatively supercoiled DNA relaxing activity, whose message is highly expressed in the testis[J]. J Biol Chem, 1998, 273 (44): 28553-28556.
5.Gibson DG, Young L, Chuang RY, et al. Enzymatic assembly of DNA molecules up to several hundred kilobases[J]. Nat Methods, 2009, 6( 5) : 343-345.
6.张阳璞,杨淑慎.几种新型植物基因表达载体的构建方法[J].生物工程学报,2015,31(03):311-327.